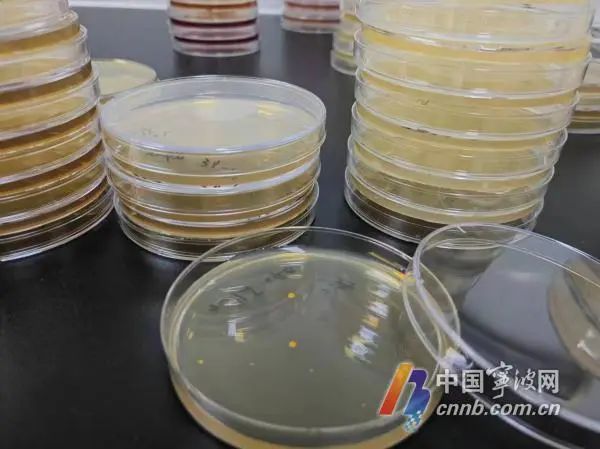
现制饮品2小时内饮用最佳?超过2小时还能不能喝?实验来揭秘→ 现制饮品2小时内饮用最佳?超过2小时还能不能喝?实验来揭秘→

饮品提醒
经常点奶茶的消费者或许接受过“请于2小时内饮用”“尽快饮用”等提醒。那么现制饮品真的是2小时内饮用最佳吗?如果超过2小时,还能不能喝?
为解除消费者疑虑,宁海县市场监管局通过实验,揭开现制饮品在不同时间和温度下的变化。

样品
实验在宁海县食品检测中心展开。工作人员从宁海城区现制饮品店随机购买了经典奶茶、杨枝甘露、时令果茶、咖啡饮品等8种饮品,在4℃下30分钟内送至实验室分别检测样品中的菌落总数、大肠菌群。

检测结果显示,随机购买的样品中均有一定数值菌落检出,大肠菌群均未检出。其中一款奶茶和一款咖啡的热饮检出菌落总数最少,仅2位数。
现制饮品归为现制现售的餐饮食品,目前尚未有此类产品的国家标准。为了评估安全性,考虑到现制饮品的产品属性接近饮料,检验人员于是参照《食品安全国家标准 饮料》的卫生指标评估。该国家标准规定饮料中菌落总数和大肠菌群的阈值不高于10000CFU/g和100CFU/g,所以以上8份现制饮品的食品安全风险都是较低的。
但如果消费者较长时间才喝上以上现制饮品,这时还安全吗?工作人员接着开展第二个实验,进一步探究温度与时间对现制饮品微生物生长的影响。
实验品
工作人员再次随机购买茉莉奶茶、经典奶茶、蜜桃果茶、拿铁咖啡,于4℃下15分钟内送至实验室。为了确保实验结果的精确性和代表性,工作人员从每种饮品中取出多杯样本,经充分混匀后再无菌分装到无菌袋中,置于4℃与25℃恒温箱中,观察其在不同时间点(1小时、2小时、3小时、4小时、5小时)的菌落总数含量(CFU/g)。

实验结果显示:
在4℃的冷藏环境下,四种现制饮料在5小时内菌落总数增长缓慢,所有样品的菌落数均保持在安全食用的界限内。
而在25℃的室温下,四种饮品在1小时内仍处于安全食用状态,1小时后急速增长,接近2小时,除带冰拿铁咖啡外其余样品的菌落总数迅速超出安全阈值,食用安全风险大大增加。
检验人员指出,以上结果为饮品未被食用的实验结果。现实生活中,情况更为复杂:饮品已开封食用、加工环境不尽如人意、存放温度偏高等,都会显著缩短饮品的保存时间。因此,消费者需要提高判断力,合理掌控饮用时间,确保食用安全。

消费提醒:
1.所购现制饮品如果暂时不喝,应4℃冷藏存放,以保持其安全性和口感;
2.常温饮品最好能在1小时内喝完,带冰饮品可适当延长。
3.选择加工环境好、证件齐全的商店购买,食用过程中如有异味应弃食。
中国宁波网记者 王岚 通讯员 石守江
点击右上角
微信好友
朋友圈

点击浏览器下方“
”分享微信好友Safari浏览器请点击“
”按钮

点击右上角
QQ

点击浏览器下方“
”分享QQ好友Safari浏览器请点击“
”按钮
